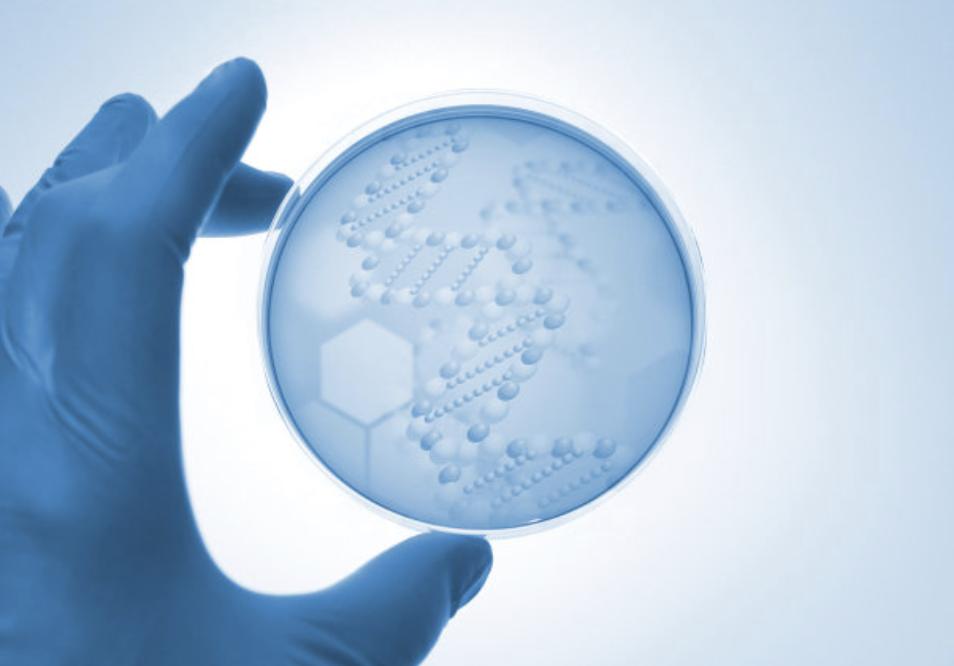
人体内的细菌在多少度以下,人体内最常见的细菌

人体内的细菌分布在哪些部位?数量有多少?
人从一出生就被微生物包围,人体与外界相接触或相通部位都存在微生物。如皮肤、口腔、呼吸道、消化道、阴道等。据瑞典科学家研究,成人的体内和体表所携带的细菌约1200克,其中分布在眼睛1克、鼻子10克、口腔20克、皮肤20克、阴道20克。由此可见,人体的细菌之多,以及变化之大。

人体被微生物包围图
人体肠道细菌最多,种类大概有数百种,重量约1000克,以个数来计约100万亿(10x 103)个,而构成人体的细胞大约为60万亿(6x1013)个。可见人体肠道内的细菌数,比构成人体的细胞数还要多近一倍。如果将这些细菌逐个头尾连接起来,其长度可达10万千米,可围绕地球两周半。人一次排便细菌的总量约是大便的1/3,其活菌和死菌总数约占人体细菌总数的一半。

肠道细菌图
肠内的细菌会不会跑到其他器官呢?
肠道作为人体最大的细菌库。人体能同如此众多的细菌和平共处、终身相伴,其原因是人体肠道有一层完好的黏膜屏障,能够阻挡这些细菌的入侵。这一保护屏障是人体在长期的生物进化过程中,和这些细菌相互适应而形成的。

细菌图
因此,在正常情况下,肠内的细菌是不会跑到其他器官去的。但是,当这个黏膜屏障受到了破坏,人体免疫功能低下的情况下,就将发生肠内细菌跑向邻近组织或经血液扩散至其他器官;进入其他器官后不一定有临床症状,但严重的会造成腹膜炎、腹腔或肝脏脓肿,甚至败血症等病症。导致肠道黏膜屏障崩溃的因素,可以是某些疾病(如阑尾穿孔),也可由腹部创伤、手术、放射治疗或免疫抑制治疗等引起。

细菌感染图
血液、器官组织中会寄生细菌吗?
一般情况下,健康人的血液和器官组织中是没有细菌寄生的。人的血液中有大小吞噬细胞,大的叫单核细胞,小的称中性粒细胞。它们数量众多,行动活泼,日夜巡逻守卫在血液中。一旦遇上细菌,就能迅速地将之包围吞噬、杀死清除掉。血液中还有溶菌酶、防御素等多种杀菌物质,能协助消灭侵入血液的细菌。我们的器官组织布满血管网,血液中的吞噬细胞和杀菌灭毒物质可以穿越血管壁进入器官组织各处。
显微镜下的细菌
因此,器官组织中任何部位的细菌,也能及时地被这些细胞和物质所杀灭。只有当细菌毒力很强数量很多,而人体的免疫力低弱时,侵入血液和器官组织的细菌不仅不被消灭,反而会生长繁殖,产生大量的毒性物质,破坏人体细胞和组织,引起严重疾病,甚至死亡。

抵抗细胞图
可见,学习人体细菌分布之后,对肠道健康,乃至身体健康以及增强抵抗力,为我们奠定一定基础。如何维持细菌菌群平衡,和平共处,相安无事,也是值得关注的。而妍益坊专注肠道健康,分享健康知识。